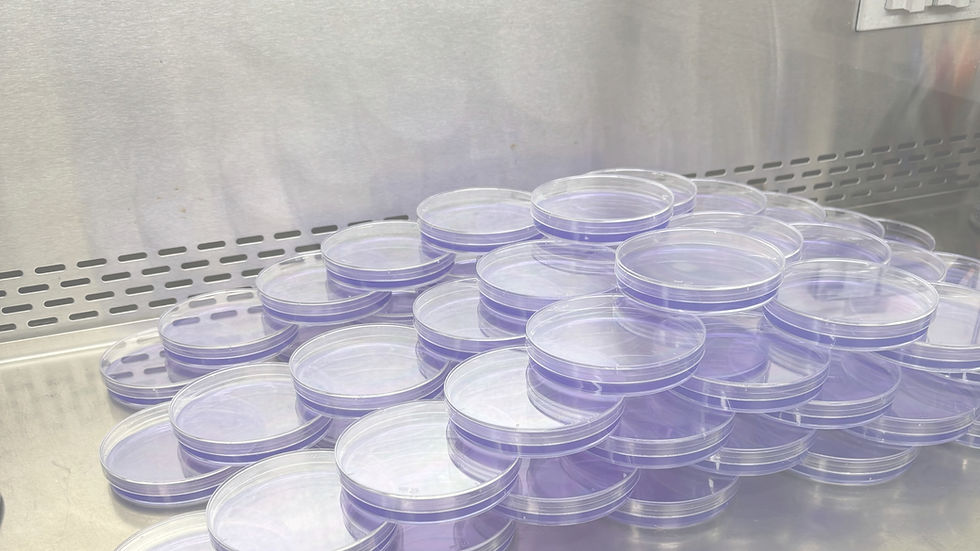

Predictive Microbiology Lab, TMU
預測微生物學實驗室
1. Microbial Risk Assessment:
Using predictive microbiology, we develop growth and inactivation models for foodborne pathogens in various food matrices. These models help predict the effects of environmental factors (e.g., temperature, water activity, salinity) on microbial growth kinetics (e.g., μmax, λ, Ymax) and thermal inactivation parameters (e.g., D-value, z-value). The models can be applied to microbial exposure assessments under different scenarios.
Currently, we have established primary and secondary predictive growth models for Staphylococcus aureus in cooked rice with pork floss and fresh vegetable salads, as well as a growth model for uropathogenic Escherichia coli in beef, pork, sugarcane juice and an inactivation model for sous-vide chicken breast. These models have been validated and can be further applied to microbial risk assessments for ready-to-eat meals, considering cold chain logistics and consumer dining habits in Taiwan.

Our research findings have been presented at:
- Food Microbiol. 2020, 89, 103374
- Food Res. Int. 2023, 164, 112316
- ICPMF12 2023, Sapporo, Japan
- Foodborne Pathog. Dis. 2023, 20, 343-350
- Food Micro 2024, Burgos, Spain
- SRA 2024, TX, USA
- Food Res. Int. 2025, 201, 115603
2. Food Toxicology and Safety Assessment
To meet the research and development needs of the functional food industry, we conduct toxicological evaluations on edible food ingredients (e.g., Gastrodia elata, mushrooms, garlic essential oil). These evaluations include:
1) Genotoxicity assays such as the Ames test, chromosomal aberration analysis in mammalian cells, and the micronucleus test in rodent peripheral blood.
2) 28-day subacute oral toxicity tests to determine the No-Observed-Adverse-Effect Level (NOAEL), supporting the development of these ingredients into functional foods.

Our research findings have been presented at:
- AsiaTOX 2018, Pattaya, Thailand
- CGCM 2018, Kuching, Sarawak, Malaysia
- Regul. Toxicol. Pharmacol. 2020, 114, 104657
- J. Tradit. Complement. Med. 2022, 12, 536-544
3. Cancer Chemoprevention by Phytochemicals
We investigate the cancer-preventive and inhibitory effects of natural products using both cell-based and animal models. Our research focuses on their ability to induce apoptosis, cell cycle arrest, autophagy, and modulate cellular signaling pathways in cancer cells.

1) Liver cancer studies:
- Bitter orange peel extract (J. Funct. Food. 2019, 60, 103404)
- Garlic (J. Tradit. Complement. Med. 2013, 3, 159-162)

2) Leukemia studies:
- Mucuna macrocarpa (Evid.-based Complement Altern. Med.
2012, 921430; Integr. Cancer Ther. 2010, 9, 298-308)
4. Functional Foods for Liver Protection and Antidepressant-like Effects
Through industry-academic collaboration projects, we assist companies in developing functional food ingredients and verifying their efficacy using animal models. This supports technology transfer and health food certification.

1) Liver protective effects:
- Wild bitter gourd extract (Food Funct. 2014, 5, 1027-1037)
- Ginseng extract (J. Ginseng. Res. 2017, 41, 316-325)
- Taiwanofungus camphoratus (J. Tradit. Complement. Med. 2020, 10, 166-174)

2) Antidepressant-like effects:
- Garlic essential oil (Food Funct. 2019, 10, 8094-8105; Phytother. Res. 2021, 35, 5133-5142)
- Gastrodia elata water extract (Curr. Pharmacol. Rep. 2018, 4, 220-237)
- Poria cocos extract (J. Ethnopharmacol. 2020, 258, 112566)
- Armillaria mellea extract (J. Ethnopharmacol. 2021, 265, 113395)
- Cordyceps militaris extract (J. Ethnopharmacol. 2021, 276, 114194)
Research Projects:
1 /
Development of growth kinetic models of uropathogenic Escherichia coli in freshly prepared fruit juices and microbial exposure assessment for their consumers
from 2024/8 to 2027/7,
supported by the National Science and Technology Council, Taiwan (NSTC 113-2320-B-038-070-MY3).
2 /
Predictive modeling of uropathogenic Escherichia coli in ready-to-eat meats
from 2020/9 to 2022/7,
supported by the Ministry of Science and Technology, Taiwan
(MOST 109-2314-B-002-282-MY2).